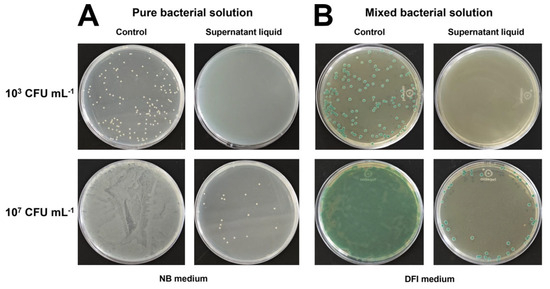

Abstract
Cronobacter sakazakii is a dangerous pathogen easily found in powdered infant formula (PIF), causing severe infections and even death in infants. Herein, a bacteriophage-immobilized magnetic nanozyme (Fe3O4@EspYZU13) was prepared for C. sakazakii detection. Bacteriophage EspYZU13 isolated and identified by our group exhibits specific lytic capacity. Fe3O4@EspYZU13 possesses remarkable enrichment capacity towards C. sakazakii, efficiently enriching different concentrations of C. sakazakii from a mixed bacterial solution. Furthermore, Fe3O4@EspYZU13 shows peroxidase-like activity, which can catalyze the 3,3′,5,5′-tetramethylbenzidine (TMB) chromogenic reaction in the presence of H2O2. Upon introduction of C. sakazakii, it can be specifically captured by Fe3O4@EspYZU13, inhibiting its peroxidase-like activity. Based on it, C. sakazakii ranging from 3.2 × 101 to 3.2 × 107 CFU mL−1 can be determined, offering a detection limit (LOD) of 26 CFU mL−1. Moreover, this reaction system keeps high specificity towards C. sakazakii, which can resist interferences of other possible coexisting bacteria. C. sakazakii in the artificially contaminated PIF can be detected, offering good recoveries (96.76% to 103.13%). These results indicate that our proposed reaction system demonstrates its practical application potential for efficient enrichment of C. sakazakii from complex samples and accurate determination of C. sakazakii in PIF.
1. Introduction
Cronobacter sakazakii (C. sakazakii), frequently identified in powdered infant formula (PIF), is an opportunistic pathogen linked to foodborne illnesses [1,2]. The contamination of PIF with C. sakazakii can potentially occur at various stages, encompassing manufacturing, processing, and transportation [3]. Ingestion of C. sakazakii-contaminated PIF by infants can result in severe infections, such as meningitis, bacteremia, and even death. Currently, available data indicate that mortality rates for infants consuming C. sakazakii-contaminated PIF range from 40% to 80% [3]. Since 1958, over a hundred cases of infections caused by C. sakazakii have been reported worldwide. Therefore, it is imperative to develop a specific and sensitive assessment technique for the detection of C. sakazakii in PIF.
Nowadays, determination of C. sakazakii primarily relies on the conventional microbial culture method [4]. Although this approach enables precise detection outcomes, it necessitates proficient operators and entails an extended culture duration (approximately 5 days), thereby significantly impeding further practical implementation. To overcome these limitations, researchers are currently engaged in the development of innovative and accelerated detection methodologies based on molecular biology, immunology, and so on [5,6]. For instance, Hu et al. proposed a rapid detection method for C. sakazakii by real-time PCR, achieving a detection limit (LOD) of 110 CFU mL−1 [7]. Chen et al. reported the utilization of microfluidic chips combined with isothermal amplification analysis for detecting C. sakazakii in PIF, offering a LOD of 2.2 × 103 CFU g−1 [8]. These methods are also limited by laborious detection procedures, expensive testing reagents, and poor detection sensitivity. Given these constraints, there is an urgent imperative to develop a pioneering detection methodology that surpasses these drawbacks and offers a more streamlined and dependable approach for determining C. sakazakii in PIF.
Nanozymes, also referred to as nanoscale enzyme mimetics, represent an intriguing category of nanomaterials that exhibit exceptional natural enzyme-like properties by seamlessly integrating the catalytic functionality of natural enzymes with the distinctive physicochemical characteristics inherent in nanomaterials [9,10]. The exceptional stability and enhanced catalytic activity of nanozymes surpass those of natural enzymes, establishing a solid foundation for their extensive application in biochemical analysis, particularly in bacterial detection [11,12]. For example, Yu’s group proposed a dual-function magnetic nanozyme for bacteria detection with a low LOD of 26 CFU mL−1 [13]. A significant drawback of nanozyme-based bacteria detection lies in their limited specificity towards target analytes. To address this issue, numerous specific recognition units, such as functional groups, aptamers, and antibodies, have been immobilized on the surface of nanozymes to enhance their specificity towards target bacteria [14,15]. For instance, Xia’s group prepared an electrochemical detector based on a functional two-dimensional metal–organic framework nanozyme for the specific detection of Staphylococcus aureus (S. aureus) via an anti-S. aureus antibody, achieving a low LOD of 6 CFU mL−1 [16]. However, these specific recognition units are still limited in terms of their limited recognition ability and high cost. Therefore, it is crucial to explore alternative specific recognition units that can overcome these drawbacks.
Bacteriophages, also known as phages, refer to a type of virus that specifically infects and replicates within bacteria [17]. Bacteriophages can be used not only to directly combat infections but also as tools for monitoring bacteria. For instance, Zhou et al. used a T2 bacteriophage modified nanostructured electrode to realize electrochemical detection of Escherichia coli (E. coli) with high specificity and sensitivity [18]. These remarkable outcomes observed can be attributed to the following significant advantages of bacteriophages: (1) bacteriophages exhibit exceptional specificity towards diverse bacterial strains; (2) the abundance and diversity of bacteriophages in natural environments provide a vast reservoir for discovering novel phage species with distinctive properties [19,20]. Inspired by these advantages of nanozymes and bacteriophages, a combination of nanozymes and bacteriophages is anticipated to achieve the highly efficient detection of C. sakazakii in PIF.
The present study proposes the utilization of a bacteriophage-immobilized nanozyme for the highly efficient detection of C. sakazakii in PIF (Scheme 1). Initially, our group isolated and identified the bacteriophage EspYZU13, which can effectively and specifically lyse C. sakazakii. Subsequently, bacteriophage EspYZU13 was immobilized onto the magnetic nanozyme Fe3O4, preparing Fe3O4@EspYZU13. Remarkably, Fe3O4@EspYZU13 exhibits exceptional peroxidase-like activity capable of catalyzing the 3,3′,5,5′-tetramethylbenzidine (TMB) chromogenic reaction. Consequently, specific inhibition of peroxidase-like activity of Fe3O4@EspYZU13 by C. sakazakii leads to specific colorimetric detection of C. sakazakii. Furthermore, Fe3O4@EspYZU13 demonstrates excellent magnetic enrichment capacity, enabling convenient enrichment of C. sakazakii from complex samples. This magnetic enrichment capability of Fe3O4@EspYZU13 enables rapid concentration of the target analytes, thereby enhancing the sensitivity of detection. Considering this, Fe3O4@EspYZU13 can be utilized for the colorimetric detection of C. sakazakii in PIF with exceptional specificity and sensitivity.

Scheme 1.
Effective enrichment (A) and colorimetric detection procedure (B) of C. sakazakii using Fe3O4@EspYZU13.
2. Materials and Methods
2.1. Chemicals and Reagents
The detailed chemicals and reagents are displayed in SM (Supplementary Materials).
2.2. Bacteria and Bacteriophage Culture
Herein, the following bacterial strains, which were stored in our lab, were utilized: C. sakazakii (CICC 21569), E. coli (CICC 10664), S. aureus (CICC 21600), Bacillus cereus (B. cereus, CICC 21261), Listeria monocytogenes (L. monocytogenes, ATCC 19111), Salmonella enteritidis (S. enteritidis, CICC 21513), and Enterobacter hormaechei (E. hormaechei, Eh-YZU05). All bacteria were cultured overnight under incubation conditions of 37 °C and a speed of 120 rpm. C. sakazakii was cultivated in nutrient broth (NB) medium, while the remaining bacteria were grown in Luria–Bertani (LB) medium [21].
Bacteriophage EspYZU13 was cultured as follows: 200 μL purified bacteriophage EspYZU13 and 200 μL host bacterium C. sakazakii were combined, followed by the addition of 10 mL LB culture medium. The mixture was then incubated at 37 °C for 8 h. Subsequently, the mixture was centrifuged at 8000 rpm for 1 min and filtered using a sterile membrane with a pore size of 0.22 nm. The resulting filtrate was stored at 4 °C for future use [21].
2.3. Synthesis of Fe3O4@EspYZU13
Magnetic nanozyme Fe3O4 was accomplished using a one-pot method according to previously reported work [22]. In brief, FeCl3·6H2O (4.4 g) and FeCl2·4H2O (1.7 g) were dispersed in 80 mL deionized water and incubated at 70 °C under magnetic agitation for 30 min. Subsequently, NH4OH solution (25~28%) (10 mL) was added into the above mixture under continuous magnetic agitation at 70 °C for 30 min. Then, ascorbic acid solution (0.085 mol L−1, 4 mL) was slowly introduced, incubating at 90 °C under magnetic agitation for 60 min. After cooling to room temperature, the resultant product was subjected to magnetic separation and subsequently washed multiple times with deionized water.
Fe3O4@EspYZU13 was synthesized through bonding between Fe3O4 and EspYZU13 [23]. Specifically, 10 mg Fe3O4 was added to a 1 mL aqueous solution containing 1-(3-dimethylaminopropyl)-3-ethylcarbodiimide hydrochloride (EDC·HCl)/N-hydroxy succinimide (NHS) (20 mg mL−1 EDC HCl and 20 mg mL−1 NHS) and 4-morpholineethanesulfonic acid (MES, 10 mmol L−1, pH 6.0). The mixture was vortexed and activated at room temperature for 30 min. Subsequently, 1.5 mL bacteriophage EspYZU13 (108 PFU mL−1) was introduced into the Fe3O4 solution, followed by incubation at 37 °C for 12 h. The obtained Fe3O4@EspYZU13 was collected by magnetic separation and then dispersed in 10 mL deionized water. The resultant Fe3O4@EspYZU13 mother solution was stored at 4 °C for further utilization. According to inductively coupled plasma optical emission spectrometer (ICP-OES) analysis, the Fe element in the EspYZU13@Fe3O4 mother solution was detected as approximately 1.38 mg g−1.
2.4. Characterization
The samples were characterized using the following equipment. Transmission electron microscope (TEM) images were acquired from a Tecnai 12 (Philips, Amsterdam, The Netherlands) at a voltage of 100 kV. X-ray diffraction (XRD) measurements: X-ray diffraction (XRD) analysis was conducted utilizing an X-ray diffractometer, D8 Advance (Bruker AXS, Billerica, MA, USA). Laser scanning confocal microscopy (LSCM) images was obtained from a laser scanning confocal microscope, LSM 880NLO (Carl Zeiss, Oberkochen, Germany). Free radicals were assessed utilizing an electron paramagnetic resonance spectrometer (EPR, A300-10/12, Bruker, Billerica, MA, USA). The Fe element in the mother solution EspYZU13@Fe3O4 was determined using an inductively coupled plasma optical emission spectrometer (ICP-OES), Perkin Elmer Optima 8000, Waltham, MA, USA. Absorbance measurements were performed using a UV-Vis spectrophotometer, UV-3200, Mapada, Shanghai, China.
2.5. Magnetic Enrichment of C. sakazakii Using Fe3O4@EspYZU13
Magnetic enrichment of C. sakazakii from a pure bacterial solution: 100 μL C. sakazakii (103 and 107 CFU mL−1) and 100 μL Fe3O4@EspYZU13 were mixed and incubated for 13 min, followed by magnetic separation. Subsequently, the supernatant liquid was diluted with a gradient of 0.9% saline solution. Appropriate dilutions were spread onto NB solid plates, then incubated at 37 °C for 18 h.
Magnetic enrichment of C. sakazakii from a mixed bacterial solution: the bacterial strains, including 1 mL S enteritidis (103 and 107 CFU mL−1), 1 mL S. aureus (103 and 107 CFU mL−1, 1 mL B. cereus (103 and 107 CFU mL−1), 1 mL L. monocytogenes (103 and 107 CFU mL−1), 1 mL E. hormaechei (103 and 107 CFU mL−1), and 1 mL C. sakazakii (103 and 107 CFU mL−1) were condensed to 1 mL mixed bacterial solution by centrifugation. A quantity of 100 μL mixed bacterial solution (103 and 107 CFU mL−1) and 100 μL Fe3O4@EspYZU13 was mixed and incubated for 13 min, followed by magnetic separation. Subsequently, the supernatant liquid was diluted with a gradient of 0.9% saline solution. Appropriate dilutions were spread onto C. sakazakii chromogenic medium (DFI agar), then incubated at 37 °C for 18 h.
2.6. Peroxidase-Mimic Activity of Fe3O4@EspYZU13
A quantity of 100 μL Fe3O4@EspYZU13 and 100 μL H2O2 (100 mM), along with 100 μL TMB (5 mM, dissolved in ethanol), was added into 2700 μL NaAc-HAc buffer solution (0.2 M, pH 4.0) in turn and then incubated for 19 min. Subsequently, the absorbance (500 nm~800 nm) of the mixture was promptly analyzed using a UV-Vis spectrophotometer.
2.7. Colorimetric Detection of C. sakazakii Using Fe3O4@EspYZU13
A quantity of 100 μL C. sakazakii solution (ranging from 9.6 × 102 CFU mL−1 to 9.6 × 108 CFU mL−1) and 100 μL Fe3O4@EspYZU13 was mixed, incubated for 13 min. After that, 2600 μL NaAc-HAc buffer solution (0.2 M, pH 4.0), 100 μL H2O2 (100 mM), and 100 μL TMB (5 mM, dissolved in ethanol) were added by turns. The resultant mixture was further incubated for 19 min before analysis using a UV-Vis spectrophotometer ranging from 500 nm to 800 nm.
2.8. Actual Food Sample Detection
Preparation of artificial C. sakazakii-contaminated PIF samples: 900 μL PIF solution and 100 μL C. sakazakii were evenly mixed.
Detection of C. sakazakii in artificially contaminated PIF samples: 100 μL artificially contaminated PIF solution and 100 μL Fe3O4@EspYZU13 were incubated for 13 min. Then, 100 μL H2O2 (100 mM), 100 μL TMB (5 mM, dissolved in ethanol), and 2600 μL NaAc-HAc buffer solution (0.2 M, pH 4.0) were added. The mixture was further incubated for 19 min before analysis using a UV-Vis spectrophotometer.
2.9. Data Processing
The data in this study were processed using Origin 2022 software (OriginLab Corporation, Northampton, MA, USA) and Excel software (https://www.microsoft.com/en-us/microsoft-365/excel).
3. Results and Discussion
3.1. Synthesis and Characterization
Fe3O4@EspYZU13 was synthesized via immobilization of EspYZU13 on the surface of Fe3O4 (Figure 1A). At first, bacteriophage EspYZU13 was isolated by our research team [24]. According to the Ninth Report of the International Committee on Virus Taxonomy, EspYZU13 is classified as a member of the Myoviridae family [25]. As depicted in Figure 1B, the obtained EspYZU13 exhibits a regular polyhedron-shaped head with a diameter of approximately 74 nm. It possesses a characteristic freely contractile tail sheath measuring around 102 nm in length. According to previous research, EspYZU13 exhibits specific lytic capacity towards its host bacterium C. sakazakii [24].

Figure 1.
Preparation of Fe3O4@EspYZU13 (A), TEM image of EspYZU13 (B), TEM images and element mapping of Fe3O4 (C) and Fe3O4@EspYZU13 (D), and XRD spectra (E) and hysteresis loops (F) of Fe3O4 and Fe3O4@EspYZU13.
Then, TEM imaging of Fe3O4 (Figure 1C) reveals its interconnected formation. High-resolution TEM analysis demonstrates a uniform distribution of Fe3O4, with a diameter ranging from approximately 2.5 nm to 6.5 nm and an average diameter of about 4.1 nm. Furthermore, element mapping confirms homogeneous distributions of carbon (C), oxygen (O), and iron (Fe) elements within the Fe3O4 structure. Additionally, XRD characterization shows five distinct characteristic peaks at 30.3°, 35.5°, 43.4°, 57.2°, and 62.8°, corresponding to crystal planes (220), (311), (400), (511), and (440) of Fe3O4 (JCPDS No.89-2355) (Figure 1E). Moreover, hysteresis loop analysis demonstrates its exceptional magnetic property (Figure 1F). These findings collectively affirm the successful synthesis of Fe3O4.
Finally, TEM imaging clearly reveals the tight binding between Fe3O4 and EspYZU13 (Figure 1D) after immobilizing EspYZU13 onto the Fe3O4. Furthermore, XRD analysis demonstrates that the structure of Fe3O4@EspYZU13 remains unchanged after covalent binding to EspYZU13, as evidenced by its consistency with that of pure Fe3O4. In addition, the diminished peak intensity of XRD suggests that the surface of Fe3O4 is enveloped by EspYZU13. These results indicate the successful preparation of Fe3O4@EspYZU13. Moreover, an hysteresis loop of Fe3O4@EspYZU13 was recorded (Figure 1F), revealing its exceptional magnetic properties after covalent immobilization of EspYZU13 and highlighting its potential for magnetic enrichment towards C. sakazakii.
3.2. Enrichment of C. sakazakii Using Fe3O4@EspYZU13
In view of the magnetic performance and specific capture ability of Fe3O4@EspYZU13, it was utilized for rapid enrichment of C. sakazakii. At first, Fe3O4@EspYZU13 was employed to enrich C. sakazakii from a pure bacterial solution. As shown in Figure 2A, both 103 and 107 CFU mL−1 C. sakazakii can be well enriched. The supernatant liquid of 103 CFU mL−1 C. sakazakii displayed undetectable levels. Moreover, the supernatant liquid of 107 CFU mL−1 C. sakazakii demonstrated only a few of colonies observed in the NB medium. Moreover, Fe3O4@EspYZU13 was utilized for rapid enrichment of 103 and 107 CFU mL−1 C. sakazakii from a mixed bacterial solution. Residual bacteria in the supernatant liquid were detected using C. sakazakii chromogenic medium (DFI medium). As shown in Figure 2B, no blue-green colonies were observed on the DFI medium from the supernatant liquid of a mixed bacterial solution (103 CFU mL−1), while only dozens of blue-green colonies were observed on the DFI medium from the supernatant liquid of a mixed bacterial solution (107 CFU mL−1). These findings underscore the robust enrichment performance exhibited by Fe3O4@EspYZU13 towards C. sakazakii.
Figure 2.
Enrichment of C. sakazakii (103 and 107 CFU mL−1) using Fe3O4@EspYZU13 from the pure bacterial solution (A) and the mixed bacterial solution (S enteritidis, S. aureus, B. cereus, L. monocytogenes, E. hormaechei, and C. sakazakii) (B).
3.3. Peroxidase-Mimicking Activity of Fe3O4@EspYZU13
The absorbance of Fe3O4@EspYZU13 + H2O2 + TMB, H2O2 + TMB, Fe3O4@EspYZU13 + TMB, and Fe3O4@EspYZU13 + H2O2 reaction systems was recorded, as depicted in Figure 3A. Notably, the Fe3O4@EspYZU13 + H2O2 + TMB reaction system exhibited a prominent absorption peak at 652 nm, indicating the formation of blue oxidized TMB (TMBox). Conversely, both the other reaction systems (Fe3O4@EspYZU13 + TMB and Fe3O4@EspYZU13 + H2O2) did not exhibit any significant absorption peak at 652 nm. And the H2O2 + TMB reaction system only showed a little absorption peak at 652 nm. These findings suggest that Fe3O4@EspYZU13 can effectively accelerate the TMB chromogenic reaction. To elucidate the underlying mechanism of Fe3O4@EspYZU13 + H2O2 + TMB, the generation of free radicals was confirmed through EPR analysis using 5, 5-dimethyl-1-pyrroline N-oxide (DMPO) as a capture agent. As depicted in Figure 3B, the resulting curve exhibits four peaks that align with the characteristic peaks of hydroxyl radical (·OH). Consequently, it can be inferred that Fe3O4@EspYZU13 possesses peroxidase-like activity capable of catalyzing the conversion of H2O2 into hydroxyl radicals, thereby oxidizing colorless TMB to yield blue TMBox (Figure 3B inset).

Figure 3.
Absorbance of Fe3O4@EspYZU13 + H2O2 + TMB, H2O2 + TMB, Fe3O4@EspYZU13 + TMB, and Fe3O4@EspYZU13 + H2O2 reaction systems (inset is the corresponding real image) (A), and EPR spectrum of the Fe3O4@EspYZU13 + H2O2 + DMPO system (inset is the inherent mechanism of TMB chromogenic reaction catalyzed by peroxidase-like Fe3O4@EspYZU13 in presence of H2O2) (B).
In addition, effect of reaction time, buffer solution pH, and storage time on the Fe3O4@EspYZU13 + H2O2 + TMB reaction system were investigated. At first, the time-dependent absorbance change at 652 nm of four reaction systems was recorded. As depicted in Figure S1, the Fe3O4@EspYZU13 + H2O2 + TMB reaction system exhibited a gradual increase in absorbance at 652 nm, ultimately reaching its maximum at approximately 19 min. Therefore, based on these findings, the optimal reaction time was determined as 19 min. Moreover, the peroxidase-like activity of Fe3O4@EspYZU13 is significantly influenced by buffer solution pH. As illustrated in Figure S2, Fe3O4@EspYZU13 exhibits its highest peroxidase-like enzyme activity at pH 4.0, thereby establishing it as the optimal reaction condition for this experimental study. Then, the storage stability of Fe3O4@EspYZU13 was also assessed. As depicted in Figure S3, the peroxidase-like activity of Fe3O4@EspYZU13 remained virtually unchanged over a period of 30 days, thus demonstrating its excellent storage stability.
Additionally, steady-state kinetics of Fe3O4@EspYZU13 were investigated at the optimal conditions. The obtained data, as illustrated in Figures S4 and S5, demonstrate conformity with the Michaelis–Menten equation. Specifically, the Km values were determined to be 1.4 mM for H2O2 and 0.17 mM for TMB, respectively, while the corresponding Vmax values were found to be 1.2 × 10−8 M s−1 for H2O2 and 3.3 × 10−8 M s−1 for TMB, respectively. Notably, as listed in Table S1, Fe3O4@EspYZU13 exhibits enzyme-like catalytic performance comparable to other previously reported peroxidase-like nanozymes [21,26], thereby significantly enhancing its potential application in the detection and analysis of foodborne pathogens.
3.4. Colorimetric Detection of C. sakazakii Using Fe3O4@EspYZU13
Given the excellent peroxidase-like activity of Fe3O4@EspYZU13, it was utilized for the detection of C. sakazakii in PIF. As depicted in Figure 4A, upon introduction of C. sakazakii (9.6 × 108 CFU mL−1), the absorbance at 652 nm of the Fe3O4@EspYZU13 + H2O2 + TMB reaction system significantly decreases. This observation suggests that C. sakazakii can inhibit the peroxidase-like activity and impede the TMB chromogenic reaction. Furthermore, we also investigated the effects of both live and dead C. sakazakii (9.6 × 108 CFU mL−1) on the Fe3O4@EspYZU13 + H2O2 + TMB reaction system (Figure S6). Compared to inhibitory effect of live C. sakazakii on this system, that exerted by dead C. sakazakii is negligible. Therefore, it can be concluded that only live C. sakazakii can hinder the TMB chromogenic system catalyzed by the peroxidase-like Fe3O4@EspYZU13, which profits from the specific recognition ability of Fe3O4@EspYZU13 towards live C. sakazakii.

Figure 4.
UV-Vis spectra of Fe3O4@EspYZU13 + H2O2 + TMB reaction system with/without C. sakazakii (A), UV-Vis spectra of Fe3O4@EspYZU13 + H2O2 + TMB reaction system with different concentrations of C. sakazakii (B), linear fitting between absorbance (652 nm) and logarithm of C. sakazakii concentration (C), and specificity of the Fe3O4@EspYZU13 + H2O2 + TMB reaction system towards C. sakazakii (D).
In consideration of the inhibitory effect of C. sakazakii on the Fe3O4@EspYZU13 + H2O2 + TMB reaction system, various concentrations of C. sakazakii were introduced. As depicted in Figure 4B, upon addition of different concentrations of C. sakazakii, a gradual decrease in the absorption peak at 652 nm of the Fe3O4@EspYZU13 + H2O2 + TMB reaction system was observed (Figure 4B). As shown in Figure 4C, the absorbance at 652 nm of the Fe3O4@EspYZU13 + H2O2 + TMB reaction system was linearly correlated with the logarithm of C. sakazakii concentration, yielding a linear equation, A652 nm= −0.090 Lg (CC. sakazakii) + 0.85, with a LOD calculated as low as 26 CFU mL−1. The specificity of the Fe3O4@EspYZU13 + H2O2 + TMB reaction system towards C. sakazakii was further investigated (Figure 5D). Minimal interference from other possible coexisting bacteria (including E. coli (9.6 × 108 CFU mL−1), S. enteritidis (9.6 × 108 CFU mL−1), S. aureus (9.6 × 108 CFU mL−1), B. cereus (9.6 × 108 CFU mL−1), L. monocytogenes (9.6 × 108 CFU mL−1), and E. hormaechei (9.6 × 108 CFU mL−1)) on the chromogenic system was observed, highlighting its exceptional specificity towards C. sakazakii. Compared with previously reported methods (Table S2), our proposed Fe3O4@EspYZU13 + H2O2 + TMB reaction system exhibits the widest detection range towards C. sakazakii [5,27,28,29]. Furthermore, the remarkably low LOD of this reaction system suggests its potential for accurately determining ultralow concentrations of C. sakazakii-contaminated PIF.

Figure 5.
TEM images of C. sakazakii (A), C. sakazakii captured by Fe3O4@EspYZU13 (B), C. sakazakii lysed by Fe3O4@EspYZU13 (C), LSCM images of C. sakazakii (D), Fe3O4@EspYZU13 (E), overlay of C. sakazakii and Fe3O4@EspYZU13 (F), and the detection mechanism of the Fe3O4@EspYZU13 + H2O2 + TMB reaction system towards C. sakazakii (G).
3.5. Sensing Mechanisms of C. sakazakii Using Fe3O4@EspYZU13
To further investigate the inherent detection mechanism of the Fe3O4@EspYZU13 + H2O2 + TMB reaction system towards C. sakazakii, TEM was further employed to characterize the compounds of Fe3O4@EspYZU13 and C. sakazakii. As shown in Figure 5A, C. sakazakii retains its complete biological structure. Upon addition of Fe3O4@EspYZU13, C. sakazakii can be rapidly captured due to the specific recognition ability of EspYZU13. As shown in Figure 5B, Fe3O4@EspYZU13 and C. sakazakii are tightly bound together. Over time, Fe3O4@EspYZU13 effectively induces lysis of C. sakazakii, leading to the release of bacterial contents (Figure 5C). The confirmation of this phenomenon was once again validated by LSCM. As illustrated in Figure 5D, C. sakazakii was stained with 4′,6-diamidino-2-phenylindole (DAPI), exhibiting a blue fluorescence signal. Additionally, Fe3O4@EspYZU13 was labeled with SYBR-Gold nucleic acid gel stain (SYBR), displaying a green fluorescence signal (Figure 5E). Furthermore, as depicted in Figure 5F, the overlapping of both blue and green fluorescence signals indicates the specific capture of C. sakazakii by Fe3O4@EspYZU13. According to the whole genome sequencing and bioinformatics analysis, EspYZU13 harbors genes encoding tail proteins (ORF03, 40, and 43). EspYZU13 can specifically recognize and capture C. sakazakii through receptor-binding proteins, thereby obstructing the catalytic sites of Fe3O4@EspYZU13 [24]. This leads to a reduction in the peroxidase-like activity of Fe3O4@EspYZU13 and hampers the TMB chromogenic reaction catalyzed by Fe3O4@EspYZU13 in presence of H2O2 (Figure 5G).
3.6. Actual Food Sample Detection
To validate the detection performance of the Fe3O4@EspYZU13 + H2O2 + TMB reaction system in practical applications, we investigate its efficacy in detecting C. sakazakii in artificially contaminated PIF. As depicted in Table 1, the reaction system demonstrates exceptional detection capabilities for artificially C. sakazakii-contaminated PIF samples, exhibiting detection recoveries ranging from 96.76% to 103.13% and a relative standard deviation below 4.21%. Moreover, the obtained results align with those acquired through the traditional PC method, affirming the reliability of our established reaction system.

Table 1.
Determination of C. sakazakii in spiked PIF samples using the Fe3O4@EspYZU13 + H2O2 + TMB reaction system.
4. Conclusions
In this work, a bacteriophage was integrated onto the magnetic nanozyme to from Fe3O4@EspYZU13. Fe3O4@EspYZU13 exhibits the following characteristics: (1) a strong and rapid enrichment ability towards C. sakazakii from complex samples, which can enhance detection sensitivity and minimize interference from other coexisting bacteria; (2) remarkable peroxidase-like activity for catalyzing the TMB chromogenic reaction, serving as the basis for colorimetric detection of C. sakazakii; (3) specific recognition capability towards C. sakazakii, thereby enhancing detection specificity. Unfortunately, the practical application of Fe3O4@EspYZU13 still requires significant advancements. In summary, these distinctive features of Fe3O4@EspYZU13 ensure its potential application in detecting C. sakazakii in powdered infant formula.
Supplementary Materials
The following supporting information can be downloaded at https://www.mdpi.com/article/10.3390/foods13233788/s1: Figure S1. Reaction time-dependent absorbance (652 nm) change of four reaction systems; Figure S2. Effect of buffer pH on the peroxidase-like activity of Fe3O4@EspYZU13; Figure S3. Storage stability of Fe3O4@EspYZU13; Figure S4. Steady-state kinetics of Fe3O4@EspYZU13 using H2O2 as substrate; Figure S5. Steady-state kinetics of EspYZU13@Fe3O4 using TMB as substrate; Figure S6. Absorbance of Fe3O4@EspYZU13 + H2O2 + TMB reaction system with dead C. sakazakii; Table S1. Comparison of kinetic parameters between Fe3O4@EspYZU13 and the previously reported peroxidase-like nanozymes; Table S2. Comparison of detection performance of our proposed Fe3O4@EspYZU13 + H2O2 + TMB reaction system with other previously reported methods.
Author Contributions
Conceptualization, X.X. and Z.Y.; methodology, X.X., Y.Z., L.G. and J.Y.; validation, Y.Z., L.G. and J.Y.; formal analysis, Y.Z., L.G. and J.Y.; investigation, Y.Z., L.G. and J.Y.; resources, X.X. and Z.Y.; data curation, X.X. and Z.Y.; writing—original draft preparation, X.X. and Y.Z.; writing—review and editing, X.X. and Z.Y.; visualization, Z.Y.; supervision, Z.Y.; project administration, Z.Y.; funding acquisition, X.X. and Z.Y. All authors have read and agreed to the published version of the manuscript.
Funding
This research was funded by the National Natural Science Foundation of China (32372368 and 32402203), the Natural Science Foundation of Jiangsu Province (BK20230586), the China Postdoctoral Science Foundation (2024M752714), the Natural Science Foundation of Yangzhou City (SZR2023000023), and the Higher Education Institutions of Jiangsu Province (23KJB550011).
Institutional Review Board Statement
Not applicable.
Informed Consent Statement
Not applicable.
Data Availability Statement
The data presented in this study are available on request from the corresponding author.
Conflicts of Interest
The authors declare no conflicts of interest.
References
- Henry, M.; Fouladkhah, A. Outbreak History, Biofilm Formation, and Preventive Measures for Control of Cronobacter sakazakii in Infant Formula and Infant Care Settings. Microorganisms 2019, 7, 77. [Google Scholar] [CrossRef] [PubMed]
- Drudy, D.; Mullane, N.R.; Quinn, T.; Wall, P.G.; Fanning, S. Enterobacter sakazakii: An Emerging Pathogen in Powdered Infant Formula. Clin. Infect. Dis. 2006, 42, 996–1002. [Google Scholar] [CrossRef] [PubMed]
- Chauhan, R.; Tall, B.D.; Gopinath, G.; Azmi, W.; Goel, G. Environmental risk factors associated with the survival, persistence, and thermal tolerance of Cronobacter sakazakii during the manufacture of powdered infant formula. Crit. Rev. Food Sci. Nutr. 2023, 63, 12224–12239. [Google Scholar] [CrossRef]
- Teramura, H.; Fukuda, N.; Okada, Y.; Ogihara, H. Comparison of Chromogenic Selective Media for the Detection of Cronobacter spp. (Enterobacter sakazakii). Biocontrol Sci. 2018, 23, 27–33. [Google Scholar] [CrossRef] [PubMed]
- Gao, S.; Wu, J.; Wang, H.; Hu, S.; Meng, L. Highly sensitive detection of Cronobacter sakazakii based on immunochromatography coupled with surface-enhanced Raman scattering. J. Dairy Sci. 2021, 104, 2748–2757. [Google Scholar] [CrossRef]
- Akineden, Ö.; Wittwer, T.; Geister, K.; Plötz, M.; Usleber, E. Nucleic acid lateral flow immunoassay (NALFIA) with integrated DNA probe degradation for the rapid detection of Cronobacter sakazakii and Cronobacter malonaticus in powdered infant formula. Food Control 2020, 109, 106952. [Google Scholar] [CrossRef]
- Hu, S.; Yu, Y.; Li, R.; Wu, X.; Xiao, X.; Wu, H. Rapid detection of Cronobacter sakazakii by real-time PCR based on the cgcA gene and TaqMan probe with internal amplification control. Can. J. Microbiol. 2016, 62, 191–200. [Google Scholar] [CrossRef]
- Chen, X.; Ma, Y.; Miao, S.; Li, D.; Zhang, Y. Visual detection of Cronobacter sakazakii on a microfluidic chip fabricated by a 3D molding method. Analyst 2023, 148, 832–838. [Google Scholar] [CrossRef]
- Wang, L.; Yang, J.; Yan, Y.; Zhang, Y.-S.; Xu, X. A smartphone-integrated colorimetric quantitative analysis platform based on oxidase-like Ce(IV)-ATP-Tris CPNs/CNF test strip for detection of inorganic arsenic in rice. Anal. Chim. Acta 2022, 1227, 340308. [Google Scholar] [CrossRef]
- Diao, Q.; Chen, X.; Tang, Z.; Li, S.; Tian, Q.; Bu, Z.; Liu, H.; Liu, J.; Niu, X. Nanozymes: Powerful catalytic materials for environmental pollutant detection and degradation. Environ. Sci. Nano 2024, 11, 766–796. [Google Scholar] [CrossRef]
- Mumtaz, S.; Wang, L.-S.; Hussain, S.Z.; Abdullah, M.; Huma, Z.; Iqbal, Z.; Creran, B.; Rotello, V.M.; Hussain, I. Dopamine coated Fe3O4 nanoparticles as enzyme mimics for the sensitive detection of bacteria. Chem. Commun. 2017, 53, 12306–12308. [Google Scholar] [CrossRef] [PubMed]
- Fu, L.; Chen, Q.; Jia, L. Carbon dots and gold nanoclusters assisted construction of a ratiometric fluorescent biosensor for detection of Gram-negative bacteria. Food Chem. 2022, 374, 131750. [Google Scholar] [CrossRef] [PubMed]
- Xue, Y.; Li, Q.; Wang, Y.; Shen, H.; Yu, S. A magnetic nanozyme platform for bacterial colorimetric detection and chemodynamic/photothermal synergistic antibacterial therapy. Microchim. Acta 2024, 191, 214. [Google Scholar] [CrossRef] [PubMed]
- Lu, C.; Tang, L.; Gao, F.; Li, Y.; Liu, J.; Zheng, J. DNA-encoded bimetallic Au-Pt dumbbell nanozyme for high-performance detection and eradication of Escherichia coli O157:H7. Biosens. Bioelectron. 2021, 187, 113327. [Google Scholar] [CrossRef] [PubMed]
- Xing, G.; Shang, Y.; Ai, J.; Lin, H.; Wu, Z.; Zhang, Q.; Lin, J.-M.; Pu, Q.; Lin, L. Nanozyme-Mediated Catalytic Signal Amplification for Microfluidic Biosensing of Foodborne Bacteria. Anal. Chem. 2023, 95, 13391–13399. [Google Scholar] [CrossRef]
- Hu, W.-C.; Pang, J.; Biswas, S.; Wang, K.; Wang, C.; Xia, X.-H. Ultrasensitive Detection of Bacteria Using a 2D MOF Nanozyme-Amplified Electrochemical Detector. Anal. Chem. 2021, 93, 8544–8552. [Google Scholar] [CrossRef]
- Lawrence, D.; Baldridge, M.T.; Handley, S.A. Phages and Human Health: More Than Idle Hitchhikers. Viruses 2019, 11, 587. [Google Scholar] [CrossRef]
- Zhou, Y.; Marar, A.; Kner, P.; Ramasamy, R.P. Charge-Directed Immobilization of Bacteriophage on Nanostructured Electrode for Whole-Cell Electrochemical Biosensors. Anal. Chem. 2017, 89, 5734–5741. [Google Scholar] [CrossRef]
- Petrovic Fabijan, A.; Lin, R.C.Y.; Ho, J.; Maddocks, S.; Ben Zakour, N.L.; Iredell, J.R.; Khalid, A.; Venturini, C.; Chard, R.; Morales, S.; et al. Safety of bacteriophage therapy in severe Staphylococcus aureus infection. Nat. Microbiol. 2020, 5, 465–472. [Google Scholar] [CrossRef]
- Dion, M.B.; Oechslin, F.; Moineau, S. Phage diversity, genomics and phylogeny. Nat. Rev. Microbiol. 2020, 18, 125–138. [Google Scholar] [CrossRef]
- Zhang, Y.-s.; Xu, X.; Yang, J.; Tan, M.; Zhou, W.; Gao, L.; Yang, Z.-q. Directional immobilization of phage on the palladium-based nanozyme for colorimetric detection of Cronobacter sakazakii in powdered infant formula. LWT 2023, 186, 115260. [Google Scholar] [CrossRef]
- Saepudin, E.; Fadhilah, H.R.; Khalil, M. The influence of carboxylate moieties for efficient loading and pH-controlled release of doxorubicin in Fe3O4 magnetic nanoparticles. Colloids Surf. A Physicochem. Eng. Asp. 2020, 602, 125137. [Google Scholar] [CrossRef]
- O’Connell, L.; Marcoux, P.R.; Roupioz, Y. Strategies for Surface Immobilization of Whole Bacteriophages: A Review. ACS Biomater. Sci. Eng. 2021, 7, 1987–2014. [Google Scholar] [CrossRef]
- Zhang, Y.-S.; Yuan, L.; Mgomi, F.C.; Chen, C.-W.; Wang, Y.; Yang, Z.-Q.; Jiao, X.-a. Characterization and comparative genomic analysis of novel lytic bacteriophages targeting Cronobacter sakazakii. Virus Res. 2023, 329, 199102. [Google Scholar] [CrossRef] [PubMed]
- Lefkowitz, E.J.; Dempsey, D.M.; Hendrickson, R.C.; Orton, R.J.; Siddell, S.G.; Smith, D.B. Virus taxonomy: The database of the International Committee on Taxonomy of Viruses (ICTV). Nucleic Acids Res. 2017, 46, D708–D717. [Google Scholar] [CrossRef]
- Zhou, W.; Wen, H.; Hao, G.; Zhang, Y.-S.; Yang, J.; Gao, L.; Zhu, G.; Yang, Z.-q.; Xu, X. Surface engineering of magnetic peroxidase mimic using bacteriophage for high-sensitivity/specificity colorimetric determination of Staphylococcus aureus in food. Food Chem. 2023, 426, 136611. [Google Scholar] [CrossRef]
- Shukla, S.; Haldorai, Y.; Bajpai, V.K.; Rengaraj, A.; Hwang, S.K.; Song, X.; Kim, M.; Huh, Y.S.; Han, Y.-K. Electrochemical coupled immunosensing platform based on graphene oxide/gold nanocomposite for sensitive detection of Cronobacter sakazakii in powdered infant formula. Biosens. Bioelectron. 2018, 109, 139–149. [Google Scholar] [CrossRef]
- Yuan, Y.; Wu, X.; Liu, Z.; Ning, Q.; Fu, L.; Wu, S. A signal cascade amplification strategy based on RT-PCR triggering of a G-quadruplex DNAzyme for a novel electrochemical detection of viable Cronobacter sakazakii. Analyst 2020, 145, 4477–4483. [Google Scholar] [CrossRef]
- Lv, X.; Gu, X.; Wang, L.; He, X.; He, C.; Zhang, J.; Zhao, L. Rapid and absolute quantification of VBNC Cronobacter sakazakii by PMAxx combined with single intact cell droplet digital PCR in infant foods. LWT 2021, 145, 111388. [Google Scholar] [CrossRef]
Disclaimer/Publisher’s Note: The statements, opinions and data contained in all publications are solely those of the individual author(s) and contributor(s) and not of MDPI and/or the editor(s). MDPI and/or the editor(s) disclaim responsibility for any injury to people or property resulting from any ideas, methods, instructions or products referred to in the content. |
© 2024 by the authors. Licensee MDPI, Basel, Switzerland. This article is an open access article distributed under the terms and conditions of the Creative Commons Attribution (CC BY) license (https://creativecommons.org/licenses/by/4.0/).